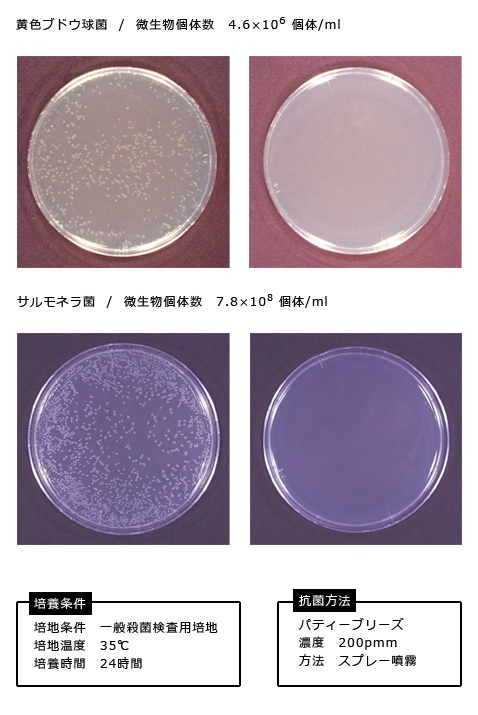
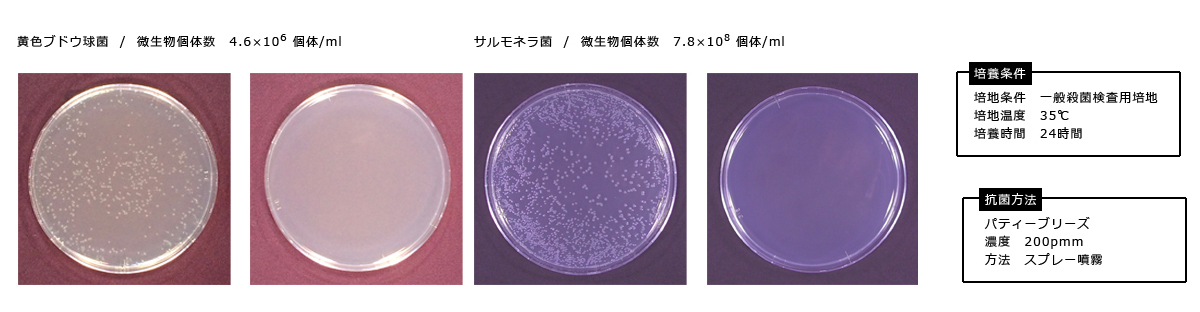

PuttyBreeze パティーブリーズ
気になる愛猫のトイレや体臭などの臭い。
いろいろな商品があるけど、猫にとって本当に安全なのか、一番気になるところですよね。
香りでごまかさない。“ニオイの原因を元から分解”食品添加物として認可を受けているものだけを原材料に使用しているので、安心・安全です。
putty(子犬)とkitty(子猫)にも使える、優しい消臭・除菌スプレー
>>PuttyBreezeのこだわり
除菌消臭後は水に戻る安全性
残留性がなく、人・家具・動物・環境への悪影響なし!
PuttyBreeze(次亜塩素水)は食品添加物で作られています。

臭いの発生源を元から瞬間消臭

臭いを元から協力消臭
猫株式会社のPuttyBreezeは、香りでごまかす消臭剤ではありません。
臭いの発生源の元となる成分・要素を分解・変質させる事により、臭いを元から消臭します。
PuttyBreezeは、アンモニア臭などの発生源を分解・変質させ、臭いを元から消臭します。
臭いの元を分解、変質することで水に戻るので、安心・安全です。
99.9% 瞬間除菌!
除菌効果で気になる雑菌・ウィルスにも有効です。

インフルエンザ・ノロウイルス・O-157など、多くのウイルスや雑菌を素早く除去します。
PuttyBreezeは、様々な殺菌・ウィルスに有効です。
細菌・ウイルスの種類や強さを問わず、どんな細菌・ウィルスにも効果を発揮してくれます。
消臭だけでなく、愛猫・愛犬の衛生管理や健康管理にも最適です。
用途によって使い分けをしなくて良いので、部屋中どこでもこれ1本で色々なところに使えるのも嬉しいポイント。

抗菌実験の結果
PuttyBreezeを噴霧する前(写真左)と、噴霧した後(写真右)の様子。

※菌の視認性をよくするため、背景に着色処理を施した画像を掲載しています。


安全だから、いろいろなニオイに使えます。

強力な消臭・除菌効果があるのに「無害・無公害」。だから、いろいろと、使えます。
例えば
・ネコちゃん・ワンちゃんのオシッコやウンチの臭いに。
・シャンプー嫌いのネコちゃん・ワンちゃんに。
・お耳・お尻・目の周りのケアにも使えます。
・ケージの消毒、トイレのお掃除に。
・オモチャやカーテン、ソファなどの布製品の消臭・除菌。
・タバコの臭いやトイレの除菌・消臭に
・キッチン・調理器具の除菌や、冷蔵庫のお掃除にも使えます。
酸性条件では、低塩素濃度でも殺菌性能があり、低刺激で臭いも残りません。
ネコちゃん以外にも、どんなところにも安心して使える、PuttyBreezeです。
まだまだあります!嬉しいポイント

肌に優しい弱酸性(pH5.5~pH6.6)
皮膚と同じ酸性なので肌へのダメージが最小限。
繰り返し手指に使えます。
高濃度だから薄めて支えて経済的
用途に合わせて薄めて使うことができるから、保存場所にも困りません!
便利な希釈目安表付き。
花粉症対策にも有効
スギ花粉のアレルゲンを不活性化します。
マスクがない時、花粉が多い時はPuttyBreezeをご利用ください。

\ 1番オススメ /
瞬間殺菌・強力消臭PettyBreeze(次亜塩素酸水)
1000ppm 10L

瞬間殺菌・強力消臭PettyBreeze(次亜塩素酸水)
400ppm 10L

瞬間殺菌・強力消臭PettyBreeze(次亜塩素酸水)
400ppm 20L
